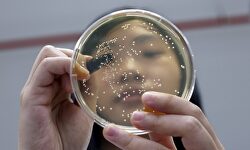

"En ningún caso C's apoyará un gobierno con Podemos. Nunca"
Libertad Digital
El portavoz de Ciudadanos ha estado en Es la Tarde de esRadio analizando la actualidad política, destacando el papel de Felipe VI en el proceso.
De lunes a jueves de 00:30 a 03:00
El tema del sexo lejos del morbo, de una forma directa, clara y respetuosa.
De lunes a viernes de 6:00 a 12:00
Información y opinión con Federico Jiménez Losantos y sus colaboradores habituales para arrancar con fuerza el día.
De lunes a viernes de 12:00 a 13:30
María José Peláez presenta un magazine cargado de humor y con los mejores invitados.
De lunes a viernes, de 15:00 a 16:00
Un programa deportivo sin periodistas deportivos. Conducido por Dieter Brandau y Juan Pablo Polvorinos.
De lunes a viernes, de 16:00 a 19:00
Información, opinión y entretenimiento de la mano de Dieter Brandau y todo su equipo.